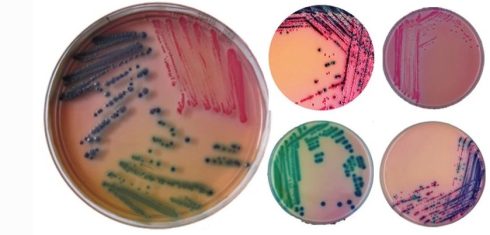

آرشیو دسته بندی: ابزار و وسایل آزمایشگاهی شامل، محلول ها کیت ها
روپوش آزمایشگاهی
روپوش سفید که در بین مردم به عنوان روپوش آزمایشگاهی یا روپوش سفید دکتر شناخته[بیشتر بخوانید]
بوریک اسید
بوریک اسید (هیدروژن بورات، boracic acid یا acid boricum) ذاتاً یک اسید ضعیف است. به[بیشتر بخوانید]
آمونیوم کلرید
آمونیوم کلرید یک ترکیب شیمیایی غیرآلی با فرمول NH4Cl است. این ترکیب معدنی sal ammoniac[بیشتر بخوانید]
EDTA فرمول ها، موارد استفاده، محلول سازی
مقدمهای بر EDTA EDTA یا اتیلن دی آمین تتراستیک اسید مولکولی است که ما آن[بیشتر بخوانید]
نیترات نقره
نیترات-نقره یک ترکیب شیمیایی با فرمول شیمیایی AgNO3 است. این ترکیب از یک پیوند یونی[بیشتر بخوانید]
تزریق هپارین
هپارین به چه دلیل برای بیمار تجویز میشود؟ هپارین برای جلوگیری از تشکیل لخته خون[بیشتر بخوانید]
10 دیدگاه
بافر TE چیست؟
بافر TE یک محلول بافری است که به طور معمول از آن در زیست شناسی[بیشتر بخوانید]
ترانس کریپتاز معکوس چیست؟
ترانس کریپتاز معکوس روند که از آن ها برای تکثیر ژنوم خود استفاده می کنند.[بیشتر بخوانید]
محیط کروم آگار کاندیدا چیست؟
محیط کروم آگار کاندیدا چیست؟ ظاهر متعارف میکروارگانیسم ها بر روی محیط کروم آگار کاندیدا[بیشتر بخوانید]
CHROMagar (Rambach آگار) چیست؟
اولین محیط کشت کروموژنیک برای تشخیص E. coli در سال 1979 توسط دکتر A. Rambach[بیشتر بخوانید]
استات سدیم
استات سدیم، با فرمول NaCH3COO و مخفف NaOAc، یک نمک سدیم اسید استیک است. این[بیشتر بخوانید]
کوماسی بلو (Coomassie blue) چیست؟
کوماسی بلو (Coomassie blue) چیست؟ رنگ های Coomassie blue خانواده ای از رنگ ها هستند[بیشتر بخوانید]
آنتی هیومن گلبولین (Anti-Human Globulin)
آنتی هیومن گلبولین (Anti-Human Globulin) گلبولین ضد انسانی یا آنتی هیومن گلبولین، در تست کومبس[بیشتر بخوانید]
محیط کشت PDA (پوتیتو دکستروز آگار): اساس، کاربرد، ترکیبات
مقدمهای بر محیط کشت PDA پوتیتو دکستروز آگار (PDA) برای کشت قارچ استفاده میشود. PDA[بیشتر بخوانید]
2 دیدگاه
لوله های اپندورف
در آزمایشگاههای تحقیقاتی و تشخیص طبی ازلولههای پلاستیکی کوچکی (لوله های اپندورف) برای کاربردهای مختلف[بیشتر بخوانید]
6 دیدگاه
لوله فالکون
لوله های فالکون از موادی به نام پلی پروپیلن یا پلی استایرن ساخته شده اند[بیشتر بخوانید]
2 دیدگاه
محیط کشت چیست؟ آشنایی با انواع محیط کشت و کاربرد
محیط کشت چیست؟ محیط کشت منبعی از مواد مغذی برای حمایت از رشد میکروارگانیسمها در[بیشتر بخوانید]
6 دیدگاه
رنگ Luxol fast blue stain چیست؟
رنگ Luxol fast blue که به اختصار LFB نامیده می شود، رنگی است که از[بیشتر بخوانید]
محیط کشت HAT چیست؟
محیط کشت HAT چیست؟ HAT Medium (محیط هیپوکسانتین-آمینوپترین-تیمیدین) یک محیط انتخابی برای کشت سلولی سلول[بیشتر بخوانید]
2 دیدگاه
فلورسئین ایزوتیوسیانات FITC
فلورسئین ایزوتیوسیانات (FITC) مشتقی از فلورسئین است که کاربردهای وسیعی دارد از جمله فلوسایتومتری می[بیشتر بخوانید]
رنگ هوچست چیست؟ Hoechst stain
رنگ های Hoechst بخشی از خانواده رنگ های فلورسنت آبی است که برای رنگ آمیزی[بیشتر بخوانید]